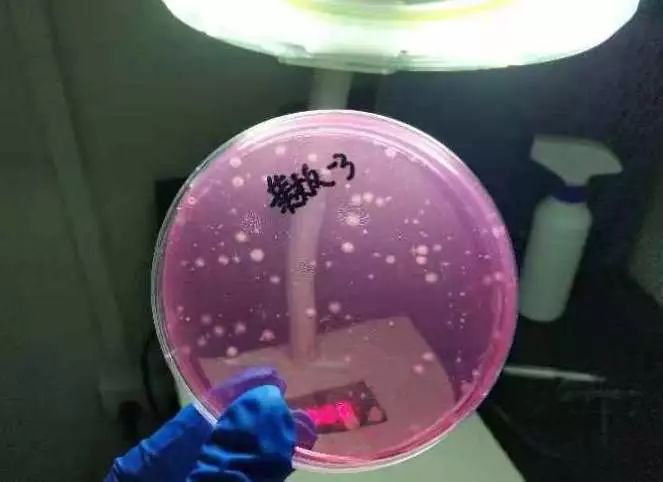
天天用的菜板，竟然有35万霉菌

菜板,每家厨房都会有。小尤鱼家的菜板已经服役2年,外观明显变色,我觉得不卫生,但妈妈却舍不得换。
“洗得干干净净的,怎么会脏?”
“旧菜板用着才顺手”

劝说无用。沾着做评测的光,小尤鱼向老板申请了个特权,把家里的2块菜板,连带着从同事家征集到的3块旧菜板,一起送到了实验室。

这5块菜板中,2块是塑料材质,3块木质。时间最短的用了半年,最长的已经用了2年。旧菜板到底多脏?实测见分晓。


检测结果扎心,旧菜板中霉菌爆表
在具有丰富检测经验的实验员建议下,我们检测了菜板的大肠菌群、霉菌以及常见的致病菌(沙门氏菌、金黄色葡萄球菌、志贺氏菌)。其他微生物检测结果还好,但5款旧菜板霉菌数量多到离谱!
实验员从菜板上取样,进行真菌的平板培养,很快就可以看到平板上出现了霉菌↓
实验进行5天后,平板上的霉菌早已密密麻麻一整片↓

虽然早有准备,但最终检测结果还是让小尤鱼大跌眼镜:

拿4#菜板举例,菜板中每50平方厘米的面积就有35万个霉菌菌群,换算下来,每平方厘米,也就是指甲盖面积大小的菜板,就有7000个霉菌菌群数。
而行业标准LY/T 2486-2015 《实木菜板》中要求菜板中霉菌菌群数要≤50CFU/g。

对比来看,这些旧菜板的霉菌数量通通爆表!
霉菌是什么?有什么危害?
霉菌,即“发霉的真菌”。霉菌在我们的生活中无处不在,他比较青睐温暖潮湿的环境,一有合适的环境就会大量的繁殖。
我们生活中,保存不当的食物发霉、潮湿墙面发霉等等,罪魁祸首都是霉菌。




而发霉的食物含有大量的霉菌,会导致消化道菌群混乱,发生食物中毒,引起急性呕吐腹泻。
而如果不幸遇到危害比较大的,比如黄曲霉毒素,对身体产生的损害,就更不容忽视。黄曲霉毒素有很强的急性毒性,早已被世界卫生组织的癌症研究机构(IARC)划为1类致癌物、毒性极强的剧毒物质。
在1974 年印度西部就发生过一起因为黄曲霉毒素导致的*案惨**。由于雨水过多,当地玉米发生严重霉变。村民食用霉变玉米后, 397人中毒,其中106人死亡,尸检及病理实验证明是由于食用黄曲霉毒素导致。
而这些霉菌爆表的菜板,每天都在和我们吃的食物接触,沾染到食物上,被我们吃进肚子里…

菜板多久换一次?怎么防霉菌滋生?
菜板多久换一次?这和每家的使用习惯有很大关系,如果你家的菜板已经出现下面这些情况,小尤鱼建议尽快换新:
• 已经明显变色、发生霉变
• 表面划痕深,污垢难以清除
•出现明显裂痕、使用时掉屑
认真清洗,正确使用可以大大增加菜板使用寿命,减少细菌滋生。参考中国农业大学食品学院营养与食品安全系副教授、食品科学博士范志红的建议,小尤鱼给大家总结了4招:
01 洗净后擦干
清洗后擦干,避免菜板长期潮湿,不给微生物滋生的机会。
02 通风干燥处悬挂放置
不使用菜板的时候,请记得要放在通风的位置,避免霉菌滋生。
03 定期洗烫杀菌
菜板上大多细菌对80℃以上的热水没有抵抗力,沸腾热水能将其“杀死”,定期用高温热水冲烫菜板,也能起到一定杀菌效果。
04 生熟分开
肉类、蔬菜类和水果最好分别使用不同菜板,同时生食和熟食也需要使用不同的菜板,这样可避免细菌的交叉传染。
检测结果摆在眼前,小尤鱼的妈妈终于用上了新菜板。

如果你家也有一个不愿换菜板的他/她,快将文章分享给他~
